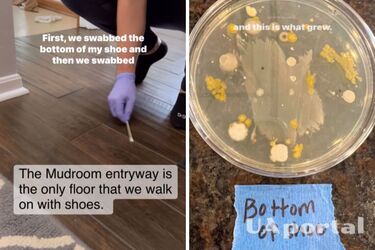
Чому не можна ходити вдома взутим

Експеримент з чашкою Петрі: В мережі показали, що буде, якщо ходити вдома у взутті
Дена О’Ніл, відома в Інтернеті як @dailydetailswithdena, провела цікавий експеримент, спрямований на визначення впливу носіння взуття у власному домі, особливо тих моделей, в яких люди пересуваються у громадських місцях. Для цього експерименту Дена використала Q-tips і чашки Петрі.
Читайте також: Як відмити душову кабіну від нальоту швидко та дієво: прості способи
У своєму відео в Instagram вона почала з очищення нижньої частини своїх кросівок, а потім зібрала зразок зі своєї туалетної кімнати, оскільки це єдина частина будинку, де взуття допускається.
Дена зазначила, що існує суперечка між людьми щодо доцільності носіння взуття вдома, особливо якщо воно було використане у громадських місцях. Вона вирішила провести експеримент, щоб з'ясувати правильну відповідь на це питання.
Для експерименту Дена взяла два зразки: перший був з низу своїх кросівок (позначений як "дно черевика"), а другий – з підлоги туалетної кімнати (позначений як "підлога брудної кімнати"). Після цього вона залишила ці зразки у "темній комірчині" на тиждень, залишаючи їх "спокійно" розвиватися.
Після тижня Дена перевірила результати експерименту і була шокована тим, що побачила в чашках Петрі – на них з'явилися жовті, сірі та білі бактерії.
Зрозумівши, що такі результати свідчать про нечистоти та бруд, Дена стверджує, що підтримує команду "не взуйся вдома". Її власний експеримент переконав її у необхідності знімати взуття при вході у власний дім.
Таким чином, зазначена блогерка наголошує на тому, що громадські місця, включаючи парки та громадські туалети, містять багато огидних бактерій, тому важливо не допускати їх до своєї оселі.
Заради гігієни та чистоти своєї оселі, Дена надає гостям спеціальні бахіли, а власне взуття вона носить лише на вулиці. Це дозволяє уникнути розповсюдження бруду та забруднення у власному домі, а також зберегти час, який можна було б витратити на частіше прибирання підлоги.
Нагадаємо, ми вже писали про те, як випрати комір та манжети сорочки.
Бажаєте отримувати найактуальніші новини про війну та події в Україні – підписуйтесь на наш Телеграм-канал!